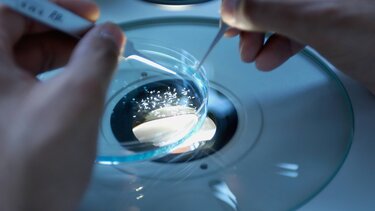
ereyna

ΕΛΛAΔΑ
"Η έρευνα είναι επένδυση και όχι πολυτέλεια"
Οι παραιτήσεις στο ΕΣΕΤΕΚ προκάλεσαν την αντίδραση της Ένωσης Ελλήνων Ερευνητών.
Αναστάτωση έχουν προκαλέσει στην επιστημονική κοινότητα της χώρας οι παραιτήσεις που σημειώθηκαν το τελευταίο διάστημα από το Εθνικό Συμβούλιο Έρευνας, Τεχνολογίας και Καινοτομίας (ΕΣΕΤΕΚ).
Σε ανακοίνωσή της, η Ένωση Ελλήνων Ερευνητών αναφέρει πως "έχει επανειλημμένα αναδείξει τα διαχρονικά και συνεχώς διογκούμενα προβλήματα που αντιμετωπίζει η Έρευνα στην Ελλάδα, όπως η απουσία εθνικής στρατηγικής, ο κατακερματισμός των ερευνητικών φορέων, η έλλειψη χρηματοδότησης, η υποστελέχωση των ερευνητικών φορέων, ο διαχωρισμός της έρευνας από την Aνώτατη Eκπαίδευση και των Ερευνητικών Κέντρων (EK) από τα Πανεπιστήμια (AEI) κ.ά.
Οι παραιτήσεις του Καθηγητή Σπύρου Αρταβάνη-Τσάκωνα (Ιατρική Σχολή, Harvard University USA), Προέδρου του Εθνικού Συμβουλίου Έρευνας, Τεχνολογίας και Καινοτομίας (ΕΣΕΤΕΚ) από το 2019, και των Καθηγητών Άγγελου Χανιώτη (Ινστιτούτο Προηγμένων Μελετών, Princeton University USA), και Πέτρου Κουμουτσάκου (Τμήμα Εφαρμοσμένων Μαθηματικών, Harvard University USA) μέλη του ΕΣΕΤΕΚ από το 2022, δεν προκαλούν έκπληξη στην ερευνητική κοινότητα, αλλά απογοήτευση.
Τρεις κορυφαίοι Έλληνες Επιστήμονες που διακρίνονται στο εξωτερικό και ανταποκρίθηκαν με ενθουσιασμό στην πρόσκληση της Ελληνικής Κυβέρνησης να συμβάλουν στη χάραξη της εθνικής στρατηγικής για την Έρευνα, την Τεχνολογία και την Ανάπτυξη της Καινοτομίας στην Ελλάδα, ήρθαν αντιμέτωποι με την αδιαφορία και την απαξίωση του έργου τους από την πολιτική ηγεσία.
Οι αιτίες των παραιτήσεων του Προέδρου και των μελών του ΕΣΕΤΕΚ (ανώτατο γνωμοδοτικό όργανο της Πολιτείας για θέματα Έρευνας και Καινοτομίας, Ν. 4635/2019) αφενός επιβεβαιώνουν τα προβλήματα και τις δυσλειτουργίες που αντιμετωπίζει η Ερευνητική Κοινότητα και συνολικά η Έρευνα στην Ελλάδα, αφετέρου, δυστυχώς, αναδεικνύουν για μία ακόμη φορά την «περιφρόνηση» της Κυβέρνησης.
Ως ΕΕΕ, στις προτάσεις/θέσεις που έχουμε διατυπώσει για την αναδιοργάνωση του Εθνικού Ερευνητικού Συστήματος και τη διασύνδεσή του με την Ανώτατη Εκπαίδευση και την Καινοτομία , υποστηρίζουμε ότι το ΕΣΕΤΕΚ θα πρέπει να αποτελεί το κύριο γνωμοδοτικό όργανο παρά τω Πρωθυπουργώ για τον Εθνικό Σχεδιασμό της Ερευνητικής Πολιτικής που θα αφορά στο σύνολο της ερευνητικής δραστηριότητας στην Ελλάδα (ΑΕΙ και ΕΚ).
Για πολλοστή φορά η Ένωση Ελλήνων Ερευνητών επισημαίνει ότι:
➢ η Έρευνα είναι Επένδυση και όχι Πολυτέλεια για τη χώρα,
➢ η Έρευνα αποτελεί προϋπόθεση για την Καινοτομία, την Οικονομική και Κοινωνική Ανάπτυξη
Για πολλοστή φορά ως Ένωση Ελλήνων Ερευνητών ζητάμε:
➢ την εγκαθίδρυση του Ενιαίου Χώρου Ανώτατης Εκπαίδευσης, Έρευνας και Τεχνολογίας,
➢ την άμεση θεσμική επαναφορά της εποπτείας Έρευνας & Τεχνολογίας, της ΓΓΕΚ και των εποπτευόμενων Ερευνητικών Κέντρων στον «φυσικό» τους χώρο που δεν είναι άλλος από το Υπουργείο Παιδείας ή σε ένα νέο Υπουργείο Ανώτατης Εκπαίδευσης και Έρευνας μαζί με τα ΑΕΙ,
➢ τον μακροπρόθεσμο σχεδιασμό και τη σταθερή, επαρκή χρηματοδότηση μιας Εθνικής Ερευνητικής Πολιτικής,
➢ ένα ευέλικτο πλαίσιο λειτουργίας και διαχείρισης κονδυλίων έρευνας χωρίς αγκυλώσεις και γραφειοκρατικές διαδικασίες."












